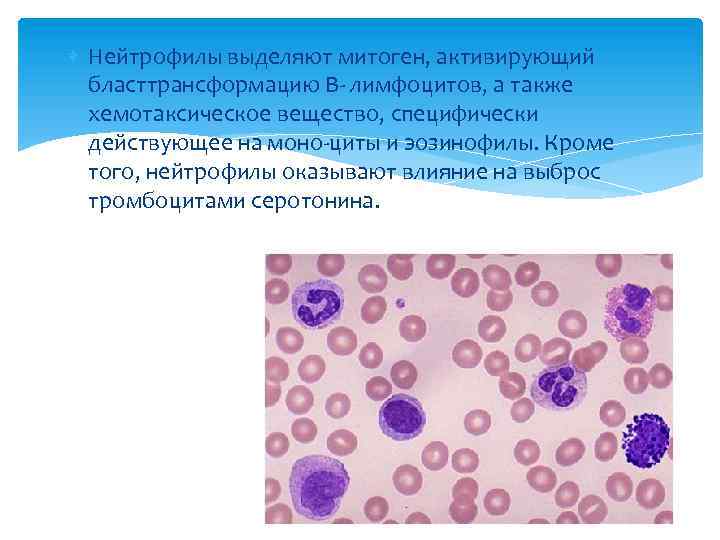
Нейтрофилы выделяют митоген, активирующий бласттрансформацию В- лимфоцитов, а также хемотаксическое вещество, специфически действующее

5.Макрофаги и нейтрофилы.pptx
- Количество слайдов: 22

Макрофаги и нейтрофилы Выполнили: Можарова Анна Габдрашитова Чулпан Группа М-33 -2 -16

И. И. Мечников, занимаясь сравнительной эмбриологией и гистологией млекопитающих, в 1882 г. открыл особые клетки среди белых клеток крови (лейкоцитов), которые, как амебы, поглощали микроорганизмы и переваривали их внутри себя. Новая мысль И. И. Мечникова состояла собственно в осознании защитного значения этого процесса для всего организма, а не пищеварительного для данной единичной клетки. Коллеги — современники И. И. Мечникова оценили эту его мысль ни много ни мало как гиппократовскую. И. И. Мечников назвал эти клетки пожирающими клетками. Гроббен и Гейдер подсказали ему греческие корни, составившие прижившийся термин — фагоциты. До И. И. Мечникова врачи считали лейкоциты крови болезнетворными.

Макрофаги Макрофаги– это группа долгоживущих клеток, которые способны к фагоцитозу

Различают две группы макрофагов -свободные фиксированные. К свободным макрофагам относятся -макрофаги рыхлой соединительной ткани, или гистиоциты; -макрофаги серозных полостей; -альвеолярные макрофаги легких. Макрофаги способны перемещаться в организме. Группу фиксированных макрофагов составляют - макрофаги костного мозга и костной ткани, - селезенки, лимфатических узлов, - внутриэпидермальные макрофаги, - макрофаги ворсин плаценты, - ЦНС.

Строение Размер и форма макрофагов варьируют в зависимости от их функционального состояния. Макрофаги имеют одно ядро. Ядра макрофагов небольшого размера, округлые, бобовидные или неправильной формы. В них содержатся крупные глыбки хроматина. Цитоплазма базофильна, богата лизосомами, фагосомами и пиноцитозными пузырьками, содержит -умеренное количество митохондрий, -гранулярную эндоплазматическую сеть, -аппарат Гольджи, -включения гликогена, -липидов и др.


Функции 1. удаляют из организма отмирающие клетки и их структуры(эритроциты, раковые клетки) 2. удаляют неметаболизируемые неорганические вещества, попадающие во внутреннюю среду организма тем или иным путем 3. поглощают и инактивируют микробы(бактерии, вирусы , грибы) 4. синтезируют разнообразные биологически активные вещества, необходимые для обеспечения резистентности организма 5. участвуют в регуляции иммунной системы 6. осуществляют «ознакомление» Т-хелперов с антигенами

Следовательно - фагоциты, являются с одной стороны «мусорщиками» , очищающими организм от всех инородных частиц независимо от их природы и происхождения, а с другой стороны участвуют в процессе специфического иммунитета путем представления антигена иммунокомпетентным клеткам ( Т-лимфоцитам) и регуляции их активности.

Нейтрофилы - наиболее многочисленная и подвижная популяция фагоцитов.

Нейтрофилы происходят из красного костного мозга, они образуются там из единой стволовой клетки, которая является родоначальницей всех форменных элементов крови.

Всего существует 6 разновидностей нейтрофилов. 1. Миелобласт 2. Промиелоцит 3. Миелоцит 4. Метамиелоцит (юные нейтрофилы) 5. Палочкоядерные нейтрофилы Метамиелоцит – одна из переходных форм нейтрофилов 6. Сегментоядерные нейтрофилы

Главной классификацией нейтрофилов является разделение по зрелости. Виды по данному показателю: -Палочкоядерные нейтрофилы. Они являются функционально незрелыми клетками крови, обладают ядром, напоминающим при визуальном рассмотрении палочку. -Сегментоядерные нейтрофилы. Представляют собой зрелые клетки, которые обладают ярко выраженным сегментированным ядром. Нейтрофилы данного вида являются основной массой лейкоцитов человеческой крови при отсутствии каких-либо болезней.

Палочкоядерные нейтрофилы у новорожденных детей составляют 5 -12%, в возрасте от 1 недели до 12 лет количество варьируется от 1 до 4%. У взрослого человека — от 1 -4% от общего числа.

Сегментоядерные нейтрофилы, норма которых варьируется в пределах от 1, 8 до 6, 5 миллиардов единиц на 1 литр крови, составляет примерно 50 -70% от общего количества.

Функции 1. уничтожение чужеродных клеток или агрегатов путем фагоцитоза. 2. нейтрофил осуществляет киллинг чужеродных клеток, как захваченных им внутрь (фагоцитированных), так и контактирующих с его оболочкой.

Процесс фагоцитоза нейтрофилами, так же как и макрофагами, состоит из шести этапов: 1. опсонизации, 2. хемотаксиса, 3. адгезии, 4. захвата, 5. киллинга 6. переваривания Отличие состоит в том, что нейтрофил может совершать свою эффекторную функцию (фа- гоцитоз) один раз, после чего он обычно гибнет

Нейтрофилы как наиболее подвижные клетки первыми приходят к месту вторжения чужеродного и стимулируют приход в данный очаг других элементов (моноцитов, эозинофилов, лимфоцитов). Выбрасывая свои гранулы в ближайшее окружение, нейтрофилы влияют фактически на все основные механизмы воспалительной реакции.
Нейтрофилы выделяют митоген, активирующий бласттрансформацию В- лимфоцитов, а также хемотаксическое вещество, специфически действующее на моно-циты и эозинофилы. Кроме того, нейтрофилы оказывают влияние на выброс тромбоцитами серотонина.

Изменение количества нейтрофилов Повышение: • инфекции (вызванные бактериями, грибами, простейшими, риккетсиями, некоторыми вирусами, спирохетами) • воспалительные процессы (ревматизм, панкреатит, дерматит, перитонит) • состояние после оперативного вмешательства • ишемический некроз тканей (инфаркты внутренних органов - миокарда, почек и. т. д. ) • эндогенные интоксикации (сахарный диабет, некроз гепатоцитов) • физическое напряжение и эмоциональная нагрузка и стрессовые ситуации: воздействие жары, холода, боли, при ожогах и родах, при беременности, при страхе, гневе, радости • онкологические заболевания (опухоли различных органов) • прием некоторых лекарственных препаратов, например, кортикостероидов, гепарина, • отравление свинцом, ртутью

Понижение: • некоторые инфекции, вызванные бактериями (брюшной тиф), вирусами (грипп, корь, ветряная оспа, вирусный гепатит, краснуха), простейшими (малярия), риккетсиями (сыпной тиф), затяжные инфекции у пожилых и ослабленных людей • болезни системы крови ( железодефицитные анемии, острый лейкоз) • врожденные нейтропении • анафилактический шок • тиреотоксикоз • воздействие цитостатиков, противоопухолевых препаратов • лекарственные нейтропении, связанные с повышенной чувствительностью отдельных лиц к действию некоторых лекарственных средств (антибиотиков, противовирусных средств, психотропных средств)

Литература 1. Медицинская микробиология, вирусология и иммунология/А. А. Воробьев, 2008, Москва 2. Иммунология/ Р. М. Хаитов, 2006, Москва 3. Иммунология в клинической практике/Под редакцией профессора К. А. Лебедева, 1996, (1 -й том)

Спасибо за внимание!
5.Макрофаги и нейтрофилы.pptx